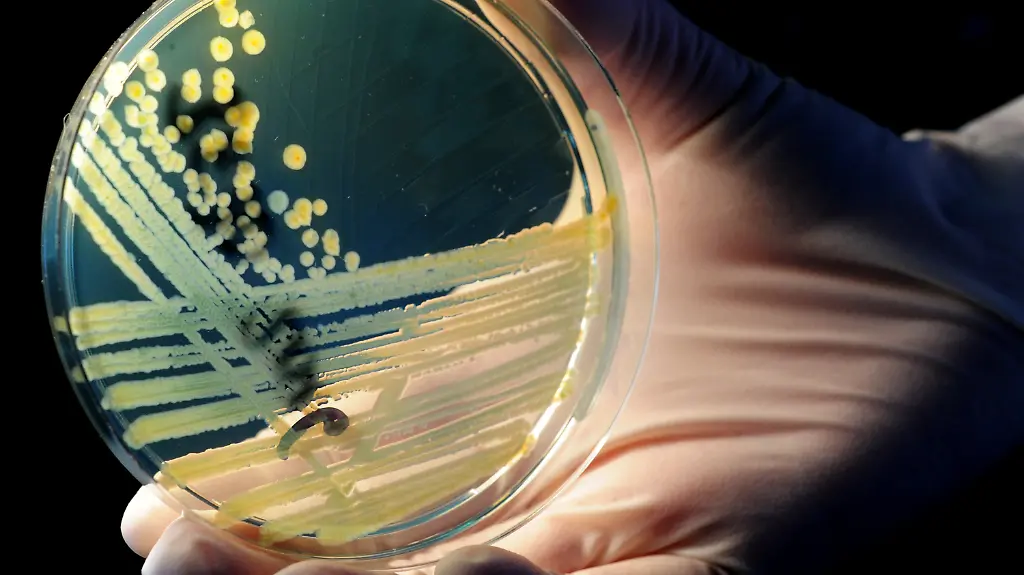
2yef4039-jpg1662585017497759299

Nachfrage nach Gemüse steigtZweijähriger stirbt an EHEC
Ein Zweijähriger aus Celle ist Deutschlands jüngstes EHEC-Opfer. Der Junge erliegt den Folgen des Darmkeims, auch sein Vater und Bruder sind erkrankt. Insgesamt geht die Zahl der EHEC-Infektionen aber zurück. Nach der Entwarnung für Salat, Tomaten und Gurken steigt die Nachfrage nach Gemüse wieder, die Bauern wollen trotzdem Entschädigung.
Zum ersten Mal ist in Deutschland ein Kind an dem derzeit grassierenden gefährlichen Darmkeim EHEC gestorben: Ein zweijähriger Junge aus dem niedersächsischen Celle starb an den Folgen des hämolytisch-urämischen Syndroms (HUS), sagte ein Sprecher des Landkreises Celle. Bislang war das jüngste vom Robert Koch-Institut (RKI) registrierte Opfer in Deutschland 20 Jahre alt. Damit steigt die Zahl der Toten in Niedersachsen auf zwölf - bundesweit wurden bislang 36 Tote gemeldet.
In der Familie sind zudem der zehnjährige Bruder und der Vater an EHEC erkrankt. Diese sind inzwischen aber nach Angaben des Amtsarztes bereits wieder auf dem Weg der Besserung. Wie sich die Familie angesteckt hat, ist noch unklar.
Fast 70 Prozent Frauen
EHEC-Infektionen treten in Deutschland jedes Jahr auf, die meisten der Betroffenen in "normalen" EHEC-Jahren sind Kinder, auch bei den Todesfällen. Der für den aktuellen Ausbruch verantwortliche Erregertyp betrifft hingegen überwiegend Erwachsene und dabei vor allem Frauen.
Insgesamt sind 3228 Erkrankungen registriert. Davon litten 781 Menschen unter der besonders schweren Verlaufsform HUS, dem hämolytisch-urämischen Syndrom. 69 Prozent davon seien Frauen. Etwa 100 Menschen in Deutschland sollen so stark erkrankt sein, dass sie eine neue Niere brauchen. Außer Nierenversagen löst EHEC laut Ärzten schwere neurologische Schäden aus. Mediziner berichteten etwa von Sprachstörungen wie bei einem Schlaganfall oder Zuckungen bis hin zu epileptischen Anfällen.
Inkubationszeit bis zu zehn Tage
Insgesamt gehen die EHEC-Infektionen aber zurück. "Die Situation scheint unter Kontrolle zu sein", sagte EU-Verbraucherkommissar John Dalli. "Das heißt nicht, dass wir in den nächsten Wochen keine neuen Fälle registrieren werden, da es eine Inkubationszeit gibt." Bis erste Symptome der Krankheit auftreten können bis zu zehn Tage vergehen.
Gesundheitsexperte Karl Lauterbach warnte vor weiteren gefährlichen EHEC-Ausbrüchen in Deutschland. "Wir müssen zum Beispiel davon ausgehen, dass dieser neue Keim nicht einfach verschwindet. Sondern der wird mit uns sein", sagte der SPD-Politiker der Nachrichtenagentur dpa. Der aktuelle Fall zeige: Auch in der Zukunft müsse man mit neuen gefährlichen EHEC-Stämmen rechnen.
Bundesgesundheitsminister Daniel Bahr will gemeinsam mit Bund und Länder das Verfahren überprüfen, wenn die Krise vorbei ist. Forderungen nach einer zentralen Stelle zur Seuchenbekämpfung erteilte der FDP-Politiker in der Zeitung erneut eine Absage.
Keim auf Lollo Rosso noch unbekannt
Derweil bestätigt Bayerns Gesundheitsminister Markus Söder, dass auf Salat von einem Gemüseproduzenten aus Fürth EHEC-Keime gefunden wurden. Der Erreger sei "wohl ungefährlich", so Söder. Es sei "äußerst unwahrscheinlich", dass es einen Zusammenhang mit dem norddeutschen Erregertyp gibt, an dem seit Mai bundesweit mehr als 3200 Menschen erkrankten und gut drei Dutzend starben. Nach Angaben des Landesamtes für Gesundheit- und Lebensmittelsicherheit (LGL) soll das Ergebnis der exakten Typisierung des EHEC-Keims Ende der Woche vorliegen. Der betroffene Betrieb und alle Waren des Erzeugers wurden vorläufig gesperrt. Aktuell sind laut Söder in Bayern 18 Menschen an der schweren Verlaufsform HUS, dem hämolytisch-urämischen Syndrom, erkrankt.
Nach der EHEC-Entwarnung für Tomaten, Gurken und Salat beginnt sich die Lage an den Gemüsetheken im Norden Deutschlands zu normalisieren. Gemüse werde wieder nachgefragt, sagte Klaus Dahmke vom Bauernverband Schleswig-Holstein. Die Direktvermarkter auf den Wochenmärkten und in Hofläden beobachteten wieder eine steigende Nachfrage.
Sprossen sind die Verursacher
Zweifelsfrei nachgewiesen wurde der aggressive EHEC-Erreger vom Typ O 104 bislang auf Sprossen aus einem Biohof im niedersächsischen Bienenbüttel als EHEC-Träger identifiziert. Deshalb sollen nun keine rohen Sprossen gegessen werden - auch keine selbst gezogenen. Nicht geklärt ist jedoch, ob Mitarbeiter den Keim eingeschleppt haben oder er durch Saatgut oder andere Quellen in den Betrieb gelangte.
Niedersachsens Gesundheitsministerin Aygül Özkan sagte, es seien inzwischen drei Sprossen-Arten auf dem Biohof eingegrenzt worden. Demnach haben fünf erkrankte oder positiv getestete Mitarbeiterinnen des Betriebes bevorzugt Sprossen von Brokkoli, Knoblauch und Bockshorn gegessen. Das Bundesinstitut für Risikobewertung (BfR) vermutet, dass das Saatgut mit dem EHEC-Keim belastet sein könnte.
EU berät über EHEC-Agrarhilfen
Experten der 27 EU-Mitgliedstaaten kommen heute in Brüssel zusammen, um über millionenschwere Entschädigungen für Gemüsebauern wegen der EHEC-Krise zu entscheiden. Für Umsatzeinbußen sollen die europäischen Landwirte laut einem Vorschlag der EU-Kommission 210 Millionen Euro statt der zunächst geplanten 150 Millionen Euro erhalten. Das Geld soll bis Juli bereitstehen und aus dem EU-Agrarhaushalt kommen.
In Deutschland sei die Vorbereitung für die nationale Umsetzung des Hilfsprogramms bereits angelaufen, teilte das Bundesverbraucherministerium mit. Ministerin Ilse Aigner sicherte den Landwirten erneut Hilfe zu. Man werde die Bauern "nicht im Regen stehen lassen", sagte sie in einem Gartenbaubetrieb in Nürnberg, den sie gemeinsam mit Söder besucht hatte.
Wegen der Seuche war der Absatz nach Behördenwarnungen vor frischem Gemüse wie Tomaten, Gurken und Salat europaweit eingebrochen - auch in Deutschland. Seit Ende Mai hätten rund 5900 Tonnen Gurken, 1300 Hektar Salat und 3500 Tonnen Tomaten vernichtet werden müssen, sagte Aigner der "Neuen Osnabrücker Zeitung". Das seien zwischen fünf und zehn Prozent der Jahresernte.